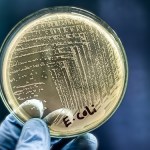
Alarmujące dane: Oporne na antybiotyki bakterie w Europie

bakteria E. coli
- Wszystkie (3)
- Artykuły (3)
Artykuły (3)
-
Bakteria E. coli w próbce z wodociągu. Wysłano alert RCB
- Środa, 22 kwietnia (20:13)
Ponad 3 tys. mieszkańców mniejszych miejscowości w okolicy Jeleniej Góry na Dolnym Śląsku jest bez dostępu do wody pitnej z wodociągu. Stwierdzono w nim skażenie bakterią E. coli....bakteria E. coli -
Alarmujące dane: Oporne na antybiotyki bakterie w Europie
- Środa, 27 listopada 2024 (11:32)
W najnowszej analizie danych z 17 krajów Unii Europejskiej i Europejskiego Obszaru Gospodarczego (UE/EOG) ujawniono niepokojące informacje dotyczące rozprzestrzeniania się bakterii...bakteria E. coli -
Pomorskie: Czerwona flaga na siedmiu kąpieliskach!
- Niedziela, 20 sierpnia 2023 (13:45)